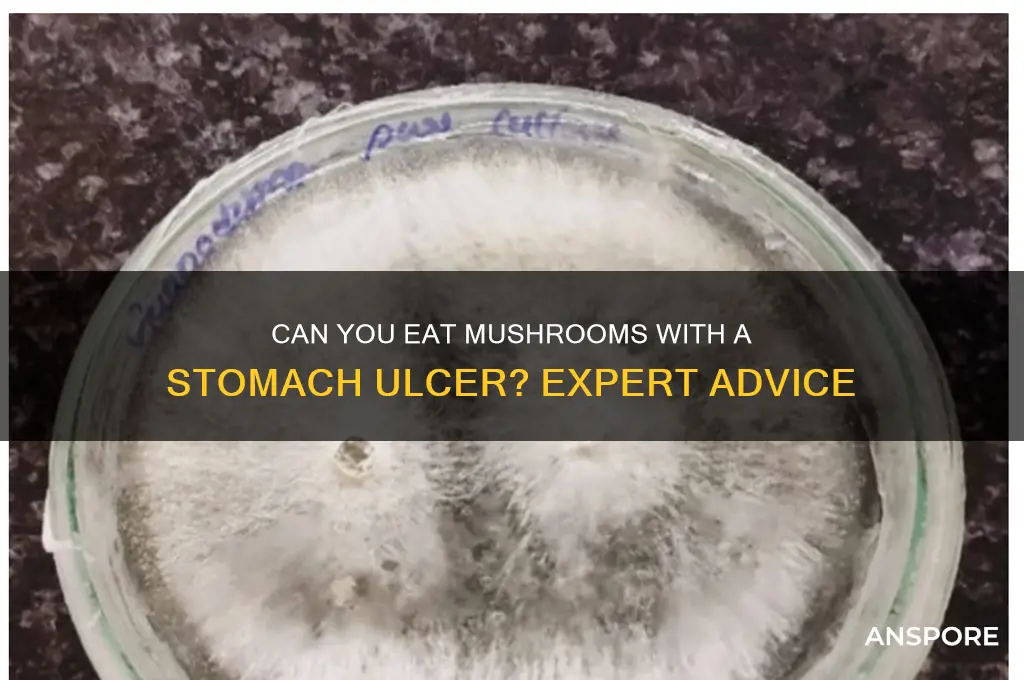
can you eat mushrooms with a stomach ulcer

When considering whether it’s safe to eat mushrooms with a stomach ulcer, it’s important to understand how certain foods can affect the gastrointestinal tract. Mushrooms are generally low in acidity and rich in nutrients, making them a potentially gentle option for some individuals. However, their fiber content and potential to cause gas or bloating may irritate an already sensitive ulcerated stomach. Additionally, some people may have sensitivities or allergies to mushrooms, which could exacerbate symptoms. It’s advisable to consult a healthcare professional or dietitian for personalized advice, as dietary recommendations can vary based on the severity of the ulcer and individual tolerance.
| Characteristics | Values |
|---|---|
| General Recommendation | Avoid or limit mushrooms if you have a stomach ulcer, as they can be difficult to digest and may irritate the stomach lining. |
| Potential Irritants | Mushrooms contain chitin, a fiber that can be hard to digest and potentially aggravate ulcers. |
| Acidic Content | Some mushrooms, when cooked with acidic ingredients (e.g., tomatoes, vinegar), may increase stomach acidity, worsening ulcer symptoms. |
| Individual Tolerance | Tolerance varies; some individuals with ulcers may tolerate small amounts of well-cooked, non-acidic mushrooms without issues. |
| Nutritional Value | Mushrooms are nutrient-dense (vitamins, minerals, antioxidants), but their benefits may not outweigh the risk for ulcer patients. |
| Cooking Methods | Steaming or boiling mushrooms may reduce irritants compared to frying or sautéing with oils or acidic sauces. |
| Medical Advice | Consult a healthcare provider or dietitian for personalized advice, as recommendations depend on ulcer severity and individual health. |
| Alternative Foods | Opt for low-acid, easy-to-digest foods like steamed vegetables, lean proteins, and whole grains instead of mushrooms. |
| Potential Risks | Overconsumption of mushrooms may delay ulcer healing or cause discomfort, including bloating, pain, or acid reflux. |
| Latest Research | Limited recent studies specifically on mushrooms and ulcers; general dietary guidelines for ulcers still advise caution with fibrous, acidic, or spicy foods. |
Explore related products
$19.99 $21.99
What You'll Learn
- Safe Mushroom Varieties: Identify mushrooms least likely to irritate stomach ulcers
- Preparation Methods: Learn cooking techniques to minimize ulcer discomfort
- Portion Control: Understand appropriate serving sizes for ulcer patients
- Potential Risks: Explore how mushrooms might worsen ulcer symptoms
- Medical Advice: Consult doctors for personalized dietary recommendations

Safe Mushroom Varieties: Identify mushrooms least likely to irritate stomach ulcers
For individuals with stomach ulcers, dietary choices are critical to managing symptoms and promoting healing. While mushrooms are generally considered healthy, their impact on ulcers varies by type. Certain varieties are less likely to irritate the stomach lining, making them safer options for those with this condition. Identifying these mushrooms requires understanding their composition and potential effects on gastric health.
Analytical Perspective:
Mushrooms with lower acidity and milder flavors tend to be gentler on the stomach. For instance, *Shiitake* and *Maitake* mushrooms are rich in beta-glucans, which have anti-inflammatory properties that may soothe the gastric lining. Conversely, mushrooms high in oxalates, like *Portobello*, can exacerbate irritation. A study published in the *Journal of Gastroenterology* suggests that mushrooms with a pH closer to neutral (around 6.0–7.0) are less likely to aggravate ulcers. Always opt for varieties with minimal acidity and avoid raw consumption, as cooking reduces their natural enzymes that might trigger discomfort.
Instructive Approach:
To safely incorporate mushrooms into your diet, start with small portions (50–100 grams per serving) and monitor your body’s response. *Button mushrooms*, due to their mild flavor and low acidity, are an excellent starting point. Steam or sauté them lightly with minimal oil to preserve their nutrients while reducing potential irritants. Avoid pairing mushrooms with acidic ingredients like tomatoes or vinegar, as this combination can increase stomach acidity. Gradually introduce other safe varieties, such as *Enoki* or *Oyster mushrooms*, which are known for their delicate texture and low irritant profiles.
Comparative Insight:
While *Reishi* and *Chaga* mushrooms are often praised for their medicinal properties, their bitter compounds can irritate ulcers. In contrast, *Lion’s Mane* mushrooms are a safer alternative, as their bioactive compounds promote gut health without causing acidity. A comparative analysis in *Nutrition Reviews* highlights that *Lion’s Mane* contains hericenones and erinacines, which support nerve regeneration and reduce inflammation, making them ideal for ulcer patients. However, always consult a healthcare provider before using medicinal mushrooms, as individual tolerances vary.
Practical Tips:
When selecting mushrooms, opt for fresh, organic varieties to avoid pesticides that could worsen symptoms. Incorporate them into bland, easy-to-digest dishes like oatmeal or rice porridge. For older adults or those with severe ulcers, blending mushrooms into smoothies can reduce fiber intake, minimizing gastric strain. Keep a food diary to track how different mushrooms affect your symptoms, and avoid any variety that causes discomfort. Remember, moderation is key—even safe mushrooms can irritate ulcers if consumed in excess.
By choosing the right mushroom varieties and preparing them thoughtfully, individuals with stomach ulcers can enjoy their nutritional benefits without aggravating their condition. Always prioritize gentle, low-acidity options and consult a healthcare professional for personalized advice.
Can Dogs Safely Eat Mushroom Soup? A Pet Owner's Guide
You may want to see also

Preparation Methods: Learn cooking techniques to minimize ulcer discomfort
Cooking mushrooms for someone with a stomach ulcer requires careful consideration of methods that reduce acidity and irritation. Steaming or boiling mushrooms instead of frying them can significantly minimize discomfort. These techniques avoid the use of oils or fats that may exacerbate ulcer symptoms. For instance, simmering mushrooms in a gentle broth not only preserves their nutrients but also creates a soothing, easy-to-digest dish. Pairing them with ingredients like ginger or turmeric, known for their anti-inflammatory properties, can further enhance their ulcer-friendly profile.
A comparative analysis of cooking techniques reveals that grilling or sautéing mushrooms at high temperatures can increase their acidity and potentially irritate the stomach lining. In contrast, low-heat methods like poaching or baking at moderate temperatures (around 350°F) maintain their texture while reducing harshness. For example, baking mushrooms with a light coating of olive oil and herbs offers flavor without the aggressiveness of frying. This approach aligns with dietary recommendations for ulcer patients, emphasizing gentle preparation over intense cooking styles.
Persuasively, adopting a mindful approach to seasoning is crucial when preparing mushrooms for ulcer sufferers. Avoiding acidic ingredients like vinegar or citrus and opting for milder alternatives such as coconut milk or almond flour can transform a dish into a stomach-friendly option. For instance, a creamy mushroom soup thickened with pureed cauliflower instead of cream provides richness without triggering discomfort. Such substitutions demonstrate how creativity in the kitchen can cater to dietary restrictions without sacrificing taste.
Instructively, here’s a step-by-step guide to preparing mushrooms for minimal ulcer discomfort: First, clean the mushrooms thoroughly to remove any irritants. Next, slice them thinly to ensure even cooking and easier digestion. Then, steam them for 5–7 minutes or boil them in a low-sodium broth for 8–10 minutes. Finally, incorporate them into dishes like oatmeal, rice, or soft-cooked vegetables, avoiding spicy or acidic pairings. This method ensures the mushrooms remain gentle on the stomach while retaining their nutritional value.
Descriptively, imagine a dish of tender, steamed mushrooms tossed with a hint of garlic-infused olive oil, a sprinkle of parsley, and a dash of black pepper. This preparation not only appeals to the senses but also adheres to ulcer-friendly guidelines. The mushrooms’ earthy flavor is enhanced without overwhelming the palate or the stomach. Such a dish exemplifies how thoughtful preparation can turn a simple ingredient into a comforting, therapeutic meal for those managing ulcers.
Can Guinea Pigs Eat Mushrooms? A Safe Diet Guide
You may want to see also

Portion Control: Understand appropriate serving sizes for ulcer patients
Stomach ulcer patients often face dietary restrictions to manage symptoms and promote healing. While mushrooms are generally considered safe, portion control is crucial. Overeating, even of healthy foods, can exacerbate discomfort. A single serving of mushrooms for ulcer patients should be limited to ½ cup cooked or 1 cup raw. This modest amount allows you to enjoy their nutritional benefits without overwhelming your digestive system.
Exceeding this portion size can lead to bloating, gas, and increased stomach acid production, potentially irritating the ulcer.
Understanding appropriate serving sizes goes beyond mushrooms. It’s about creating a balanced diet that supports healing. For instance, pairing a small portion of mushrooms with lean protein like grilled chicken and steamed vegetables ensures a nutrient-dense meal without overloading your stomach. Think of it as a delicate dance – nourishing your body while giving your ulcer the space it needs to recover.
Consulting a registered dietitian can provide personalized guidance on portion sizes and meal planning tailored to your specific needs and ulcer severity.
Portion control isn't just about quantity; it's about mindful eating. Eat slowly, chew thoroughly, and listen to your body's hunger cues. Stop eating before you feel full, as the sensation of fullness can lag behind actual stomach capacity. Using smaller plates and bowls can visually reinforce appropriate portions and prevent overeating. Remember, healing an ulcer requires patience and a commitment to gentle, mindful dietary choices.
Are Canned Mushrooms Gluten-Free? A Comprehensive Guide for Dieters
You may want to see also
Explore related products

Potential Risks: Explore how mushrooms might worsen ulcer symptoms
Mushrooms, while nutrient-dense and often celebrated for their health benefits, can pose risks for individuals with stomach ulcers. Their high fiber content, particularly in raw or undercooked forms, can irritate the gastric lining, exacerbating inflammation and discomfort. For ulcer patients, this irritation may prolong healing or intensify symptoms like pain, bloating, and nausea. Cooking mushrooms thoroughly can reduce fiber-related risks, but even then, individual tolerance varies. Those with active ulcers should monitor their body’s response carefully, as even small portions might trigger adverse effects.
Another concern lies in mushrooms’ naturally occurring compounds, such as chitin, a component of their cell walls. Chitin is difficult to digest and can increase stomach acidity, a known aggravator of ulcers. This is particularly problematic for individuals with *Helicobacter pylori* infections, a common cause of ulcers, as heightened acidity can worsen bacterial activity. Studies suggest that limiting chitin-rich foods, including mushrooms, may support ulcer management. If mushrooms are consumed, pairing them with acid-reducing foods like ginger or fennel might mitigate potential harm, though consultation with a healthcare provider is advised.
The method of preparation also plays a critical role in determining mushrooms’ impact on ulcers. Fried or heavily seasoned mushrooms can introduce additional irritants, such as fats and spices, which are known to stimulate acid production. Steaming or boiling mushrooms is a gentler alternative, as it minimizes added stressors on the stomach. However, even with careful preparation, some individuals may still experience sensitivity. Keeping a food diary to track symptoms after mushroom consumption can help identify personal thresholds and inform dietary choices.
Lastly, the type of mushroom matters. While common varieties like button or cremini mushrooms are generally mild, exotic or wild mushrooms may contain compounds that further irritate the stomach. For instance, certain species contain hydrazines or other toxins that can cause gastrointestinal distress even in healthy individuals. Ulcer patients should avoid foraging for wild mushrooms and stick to well-known, commercially cultivated varieties if they choose to include them in their diet. Prioritizing safety and moderation is key to minimizing risks while exploring dietary options.
Exploring Legality: Can You Buy Psychedelic Mushroom Spores?
You may want to see also

Medical Advice: Consult doctors for personalized dietary recommendations
Stomach ulcers demand a tailored approach to diet, and mushrooms often spark debate. While some sources suggest avoiding them due to potential irritation, others highlight their nutritional benefits. This conflicting advice underscores the need for individualized guidance. A doctor or dietitian can assess your specific ulcer condition, considering factors like severity, medications, and overall health, to determine if mushrooms fit into your diet.
Self-diagnosis and generic dietary rules can be risky. What works for one person with a stomach ulcer might exacerbate symptoms in another. For instance, while some tolerate cooked mushrooms well, others may find even small amounts trigger discomfort. A healthcare professional can provide clarity, ensuring your dietary choices support healing rather than hindering it.
Imagine navigating a complex maze without a map. That’s akin to managing a stomach ulcer without expert advice. Doctors and dietitians act as your guides, offering evidence-based recommendations tailored to your unique needs. They can advise on portion sizes, preparation methods (e.g., sautéing vs. raw), and timing of mushroom consumption relative to meals or medications. For example, pairing mushrooms with a bland food like rice might reduce the risk of irritation.
The internet overflows with dietary advice, but much of it lacks the nuance required for conditions like stomach ulcers. Relying solely on online sources can lead to confusion or harm. A personalized consultation ensures you receive accurate, actionable guidance. Your healthcare provider might also recommend dietary adjustments beyond mushrooms, such as limiting acidic foods or increasing fiber intake, to create a comprehensive plan for ulcer management.
Ultimately, the decision to include mushrooms in your diet with a stomach ulcer isn’t one-size-fits-all. It hinges on professional evaluation and ongoing monitoring. Start by scheduling an appointment with your doctor or a registered dietitian. Bring a food diary to discuss your current diet and any symptoms. Together, you can craft a plan that balances nutritional needs with ulcer care, ensuring your dietary choices promote healing and comfort.
Creamy Twist: Adding Mayo to Cream of Mushroom Soup?
You may want to see also
Frequently asked questions
It’s generally best to avoid mushrooms if you have a stomach ulcer, as they can be difficult to digest and may irritate the stomach lining.
While some mushrooms like shiitake or button mushrooms may be less irritating, it’s still advisable to avoid them until your ulcer heals, as individual tolerance varies.
Yes, mushrooms can potentially worsen symptoms like pain, bloating, or acidity due to their fibrous nature and potential to stimulate acid production.
Cooking mushrooms may make them easier to digest, but it’s still recommended to avoid them if you have a stomach ulcer to prevent irritation or discomfort.











































